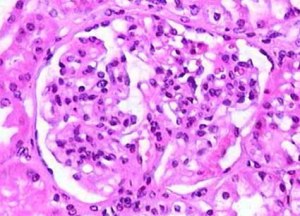
Kidney with IgA. The black is the proteins....

***UPDATE***
I HAVE BEEN GETTING A LOT OF EMAILS LATELY ABOUT THIS POST. THEY ALL ARE ABOUT ONE THING…WHAT ESSENTIAL OILS DID I USE TO CURE MY DAUGHTER’S IgA?
I FEEL I HAVE SOMEHOW NOT BEEN AS SPECIFIC AS I THOUGHT I WAS ABOUT EVERYTHING WE DID TO PUT MY DAUGHTER’S IgA INTO REMISSION. I DECIDED TO REWRITE THIS POST TO CLEAR UP ANY CONFUSION. EVERYTHING WE DID IS LOCATED THROUGHOUT THIS BLOG.
PLEASE KNOW THAT THIS DID NOT HAPPEN OVERNIGHT. THIS TOOK US SEVERAL YEARS OF BEING VERY STRICT AND IMPLEMENTING EVERYTHING AS A WHOLE TO GET TO WHERE WE ARE TODAY. IT WAS NOT AN EASY ROUTE TO GO DOWN. WE MADE MANY THINGS A PRIORITY THAT WERE NOT PRIORITIES BEFORE.
I DID NOT USE ANY ESSENTIAL OILS TO “CURE” MY DAUGHTER’S IgA NEPROPATHY. ALTHOUGH I LOVE MY ESSENTIAL OILS, THEY ARE NOT A CURE ALL FOR ANYTHING. I USE THEM IN MY DAILY LIFE AND FEEL THAT THEY ARE AMAZING….BUT SERIOUSLY LIKE I SAID THEY ARE NOT A CURE. ANYONE THAT TELLS YOU OTHERWISE IS NOT TELLING YOU THE TRUTH. YOU CAN TAKE OILS INTERNALLY AT YOUR OWN RISK. MANY CONSULTANTS WILL TELL YOU IT IS SAFE. I WILL TELL YOU THAT OILS ARE EXTREMELY POWERFUL AND TO USE WITH CAUTION.
The most important thing to remember is that I did everything I could think of to strengthen our immune systems and guts. It all acts as a whole. When you have an autoimmune disease, you have to think about things differently. Illnesses hit harder and take longer to get over. When you have IgA Nephritis, the more frequently you are sick the more irritated the kidneys become. The more irritated the kidneys become, the more damage to them and possibly other organs.
I WILL REPEAT THIS AGAIN IN CASE YOU MISSED IT IN ALL THE RED BOLD CAPITAL LETTERS ABOVE…I DID NOT USE ESSENTIAL OILS TO “CURE” MY DAUGHTER’S IGA NEPHROPATHY. I USE THEM IN OUR DAILY LIVES THOUGH…
You have heard me say over and over in this blog that the personal choices you make in your life with regards to foods, cleaners, and medications can affect you in ways you never dreamt were possible. Listening to your body is the key to helping you stay healthy and can truly change your life.
My Daughter’s Story
Here is an inside glimpse at what my oldest daughter’s world has been like for the last 19 years. A story that she seldom shares with close friends and family. I have been given special permission to share parts of it with you all now.
Since as far back as I can remember, my oldest daughter has had health issues of various forms. One of my roles in her life is to be her advocate and not accept what goes against my gut feeling especially when it comes to her health.
Where It Began
My oldest daughter had gotten sick with pneumonia and a major sinus infection when she was little. She was put on antibiotics for the usual 2 weeks. She seemed to get better. However, within 2 weeks after ending the antibiotic, she was sick again. I took her back into the doctors and she was again placed on antibiotics. She seemed to get better, however, within 2 weeks of being off the antibiotics, she was sick again.
This went on for weeks. Those weeks turned into months. Those months turned into over a year. At my wits end, frustrated, dealing with the side effects of the antibiotics, a constantly sick child, and no answers, I began demanding to see specialists when my daughter’s pediatricians failed us. Because she had insurance through the state, I had to go through her pediatrician for referrals. They were denying my requests.
I was told by the pediatricians in the office that I was…
- A psychotic mother
- Boarding on Munchhausen
- Abusive
- Neglective
- Obsessive
All I begged for was to have her tested to see what was REALLY going on, not to have her prescribed another antibiotic and sent home. Let’s just say, I was not well liked! I was passed around through the practice with notes of my insanity written in her charts. Unfortunately, we lived in a small town with only 2 pediatricians offices that took the state medical card. This practice was the better out of the 2. I continued to fight for her. On one of our bi-monthly doctor’s appointments (Yes, it was that bad!!) the doctors in the office had finally had enough of me and gave me to the nurse practitioner in the office warning her about how crazy I was. I heard them in the hall talking. She walked in and saw something that NONE of the other actual doctors in the practice saw.
The first part of our mystery unfolded.
She asked if I had a picture of my daughter from before she got sick. It just so happened that I did. When I showed her my pics, she noticed that my daughter’s sinus passages were really puffy and her face appeared swollen now and not in the pictures she was looking at. She sent us for scans immediately. Turns out my daughter had SEVERELY impacted sinuses aka one hell of a sinus infection. The antibiotics she was put on for the past year were not strong enough for her body to heal itself and the infection was returning within the 2 weeks after the course was done. She prescribed another round of stronger antibiotics for a longer time frame and the infection cleared up.
I felt vindicated and my daughter was no longer sick with the reoccurring sinus infection.
We continued to see the nurse practitioner, Cindy (ONLY) the entire time we lived in that small town. It was heartbreaking when we finally left the practice. However, it became too hard to do after we moved to another state.
The Hits Keep Coming
My daughter continued to get sick constantly. If there was a cold or virus going around she was guaranteed to get it. The symptoms would be more severe and it would last twice as long for her. No matter what it was, allergies, colds, viruses, flu. When we tried to figure out the why but there were never any answers for us. All we were told is that because she was a preemie at birth that maybe this was just one of the “side effects” of that.
Fast forward to her preteen years of February 2010. I received a phone call from my daughter’s school nurse telling me that she had collapsed and passed out in the hallway. The nurse told me that she thought she was faking it to get out of an exam. I took her immediately to our family doctor where she was diagnosed with a major kidney infection. The doctor was shocked that we did not know she had an infection or any symptoms of one at all. However, it was when she peed blood for the first time after the kidney infection had cleared up, that we knew we were in for something altogether different.
Our World Crashing Down Around Us
The first time she peed blood, her urine was checked and there were high levels of proteins in the urine along with blood. We were immediately sent to our local hospital and then to hospitals and specialists in Washington DC and Baltimore. It was crazy. She had just gotten over strep throat. X-rays on her kidneys also revealed fluid filling the 1/4 lower section of one of her lungs. At first, they thought it was pneumonia. However, that was not the case. It was actually blood in her lungs. That got all our attention, let me tell you!!! They ran test after test on her. We were being thrown names of all kinds of diseases and ailments that they thought it was. NONE were what a parent wants to hear and with the list growing we were unsure what the next course of action needed to be.
After several weeks and several specialists later, she was finally diagnosed with an autoimmune disease….IgA Nephritis (also known as IgA Nephropathy). IgA Nephritis is a kidney autoimmune disease. There is no cure for it.
I have been asked not to share all of the issues she faces daily. Many are just too personal for a 19-year-old to share. So the only thing I will share with you is that she gets sick often, it lasts at least 2 times longer and is more severe in symptoms. I will also tell you that she suffers flair ups when she gets sick. The only thing I will share about her flair ups, is that she does pee a HUGE amount of blood.
The effects compound in the body creating long term health issues (High blood pressure, swelling of the extremities, kidney failure, other organ failures, just to name a few).
What is IgA Nephritis and how is it diagnosed?
I am going to tell you the gist in nonmedical jargon…..
Whenever you get sick, your body does multiple things at once to try to stop the infection. One of them is for your kidneys to send out a protein called IgA throughout your body. The IgA attaches itself to the germs and your kidneys basically give a loud whistle and the IgA coming running back with the germs in tow and your body gets rid of it in the urine. AKA you pee it out! Just one of the reasons you always hear to push fluids when you are sick! Well, the issue with IgA Nephropathy is that the body just kind of likes to continue to produce the IgA protein ALL THE TIME! Your urinary tract is NOT impressed, with it. They continue to bleed in protest. Normally it is small amounts seen only under a microscope. However, when you get sick, it is a whole different story! Since you usually produce this protein in mass amounts when you are sick, the proteins are increased with illness. The kidneys do not know what to do at that point. As I have already said, they are consistently bleeding in small amounts. When you get sick they get REALLY irritated and bleed a LOT. This is when you can see the blood in the urine. In my daughter’s case, it looked like you had dumped an entire IV bag of blood in the toilet when she peed.
Her kidneys were really pumping it out each time she got sick. The worst part though is that there is only so much blood your body can reabsorb at once. When my daughter would get sick and have a flair up, the blood from the kidneys would push up and her lungs would absorb it. That is what the fluid was in her lung on the X-rays.

I will also tell you that when you go online and try to research IgA Nephritis, the information you find often contradicts itself. From the age that is most often diagnosed, to the treatment, and even the sex of those affected with this the most.
What did and does all this mean for my daughter’s overall health?
She sees a specialist who monitors her and makes sure we are doing everything we can. Remember there is no cure for it. All we do is manage her symptoms. If she has a flair up, she has to get blood work, scans, and urinalysis tests immediately. She has to drink a certain amount of fluids daily. It also means that eventually she will have to have kidney dialysis, multi-organ transplant, can’t drink alcohol ever, and the most painful one for her was being told that she would not be allowed to get pregnant. These were just some of the issues she would face. It also meant that her immune system would always be compromised. She will continue to get sick constantly and that it would be harder for her body to fight illness.
This was the second part of the mystery that had plagued us since she was a baby.
We now understood why she was sick ALL. THE. TIME.
I could accept almost all of the things that were thrown at us.
EXCEPT for one thing.
THERE. IS. NO. CURE.
This is not something I would or could accept. I looked at it differently and decided to do all that I could think of to help my daughter beat what we were being told was unbeatable….
THE CHALLENGE HAD BEEN LAID OUT….
THE CHALLENGE WAS EXCEPTED!
What did I change?
Diet, cleaners, medications, the way I treat us when we are ill.
Diet
The first thing we did was overhaul our diet. We loved, LOVED, L.O.V.E.D. our processed foods. Did I mention LOVED??? This was one of the hardest things we changed. We switched to a Real Whole Foods diet and then incorporated the Feingold Diet into that. I cut out processed foods and also took out the artificial sweeteners, additives, preservatives, nitrates, nitrites, sodium benzoate, high fructose syrup, corn syrup, dextrose, and more. We had multiple things going on with various family members all at once. I knew that gut health was vital in helping all of us to get to where we needed to get to. Basically, we cut out all processed foods and as many preservatives and additives as we were able to. Processed foods to us now are pickles, tortillas, cheeses, noodles. We began shopping local and buying as fresh as possible. We stopped eating out. I am not talking about here and there type things. There is no cheating. No shortcuts. I moved into making almost everything from scratch. What I can’t make has 5 ingredients or less in it and I know what they are and why they are in there. Boxes and canned foods are almost non-existent in my home. I forced her to drink tons of water. We eat all natural prebiotics and probiotics. I discovered the power of fermented foods and the correlation between the gut and the immune system. My thought was that the healthier she eats the less she will get sick. The less she gets sick, the more her body can heal itself. The more her body can heal herself, the stronger her immune system will become.
Food Storage Containers
We moved away from all plastic containers and water bottles opting for glass instead.
Household Cleaners and Other Chemicals
This one was another one I had to get used to. We now make our own cleaners. Trading in the store bought chemicals for the homemade all natural ones instead. I add essential oils to my cleaners. We got rid of the smell good candles and plug-ins. Air fresheners and Lysol are gone as well. If I want to make the house smell good, I use essential oils and one of my diffusers. Laundry detergents and dish soaps are all free and clear of scents and colors. We also removed as many of the carpets as we were able to in our home replacing them with wood and laminate flooring. We change out of air filters in our home more frequently than is suggested
Beauty Products
We make as many of our beauty products as possible from scratch. If we can not, then we are very careful with ingredients. The fewer the better. I add essential oils to our beauty and skin care products. Not because of her IgA but because of their therapeutic properties.
Other The Counter Medications and Prescriptions
I started using homeopathic remedies as my first line of defense against colds, viruses, and allergies instead of running to the pharmacy and doctors offices. Things like teas with BUCKWHEAT honey and lemon or increasing pickles (pickle juice), dark chocolate, etc for cold and cough relief, detox baths with Epsom salt, baking soda, and essential oils in them instead of Vicks. From scratch chicken noodle soups. Pushing fluids and lots of rest when sick. We use essential oils in diffusers in the rooms that we are in. We also incorporate sinus and throat massages when we are sick.
If we need a supplement or a vitamin, we work it out with the doctors to let us try increasing foods that contained them first before putting us on meds or supplements. If we do need to go on them, we take with natural prebiotic and probiotic foods (fermented foods, dark chocolate, plain greek yogurts).
Seasonal allergies are treated with essential oils, rest, detox baths, netti pots, and staying indoors with the windows and doors closed when needed. This includes keeping our windows and the sunroof of our vehicles closed when allergies are at their worst.
During the fall (a week after school starts) until the late spring we rarely go out to places when they are busy. We are semi-hermits. We do this to limit the germ exposure. Sounds crazy to many but when you have an autoimmune disease, it is not. We are trying to keep the immune system as healthy as we can. My kids and I are not cooped up. We are just smart about when we do things. Movies are matinees when not as many people are there. Grocery shopping is done when the stores are not as busy. Play dates are random and far between during this time of year. Parks are gone to when not a lot of kids are there. Museums and aquariums are done during the week and as early in the day as possible. We wash our hands frequently and use a lot of hand sanitizers when in public.
Bags, Purses, and Shoes
Shoes are taken off at the door while purses, book bags, diaper bags and grocery bags do not touch tables and counters. All but grocery bags are actually left at the entry way of my home on hooks and emptied there as needed. Grocery bags are emptied on either a chair or while they are on the floor. They are folded and taken back to the entryway of my home immediately.
It has now been 5 years since she had her last flair up and 2 years since her last formal specialist check up. At her last check up we were in awe with what we were told.
It appeared as though we either had brought the IgA Nephropathy into remission or completely reversed it. My daughter’s specialist decided to run more tests and do another urinalysis to see where the levels are and to confirm what she believed that we were able to do. I waited to finish the original post until we knew what the outcome of those test results were. They ran and then re-ran the tests to make sure that the test results were accurate.
We were hopeful.
We were affirming.
We were setting it into motion.
We were staying positive!!!
THEN THE CALL WE HAD BEEN WAITING FOR AN ENTIRE WEEK + HAPPENED….
- WE REVERSED THE IgA IN MY DAUGHTER!!!!
- AS IN GONE!!!!
- NO PROTEINS IN HER URINE!!!!
- KIDNEYS WERE BACK TO FUNCTIONING THE WAY THEY ARE SUPPOSED TO!!!!
- 100% GONE!!!!!!!!!!!!!!!!!!!!!!!!!!
What Did This Mean For My Daughter?
- She is now allowed to get pregnant. She will need to be monitored more closely during her pregnancies but she can now have a baby if she chooses.
- She can now take medications and prescriptions if she needs to.
- She can live a normal life.
The only thing we have been warned about is that if she no longer decides to follow the path of “treatment” that we figured out for her, her IgA Nephropathy can return with a vengeance. We were also told that unfortunately there is long term damage to her kidneys and lungs that we can not do anything about.
Want more information on IgA Nephropathy????




This is my favorite post, I am so happy for you and your family and the amazing things you have accomplished and the life you give to your girls. You are truly a hero for them.
You are INCREDIBLE Tracy!!! Thank you!!!!!!
Thank you for sharing your story. My 67 year old husband was just diagnosed. We are looking for holistic help.
You are so welcome. I hope your husband is able to find what works best for him so that he can reverse his.
How is this possible?? Can you please tell me more in detail what you ate and did? I’m 35 years old diagnosis a uear ago in May and have completely declined in less then a year from GFR of 29 to 23. For I am a single mother of two young girls and have made a complete turn around of life. W less fast food no alcohol and taking my bp meds bc this causing hypertension. I would love to know more details of what you have done. My protein has split in half but still my kidney funtion is really declined. What kind of holistic for example did you use?
First off, please know that this did NOT happen overnight. It took us several years to get my family’s and my daughter’s immune system and health to where it needed to be for her to overcome the IgA Nephropathy and us to overcome other health issues we had going on. We did it as a family. There was NO quick fix or miracle drugs. It was hours upon hours of research done on my part. Our lifestyle is not for most people. I hear all the time that they do not have the time to do what I do. I usually will call bullshit on that. There are 5 of us. One with special needs. I am able to do it because I chose to put our diet and lifestyle as a priority. This meant finding the time to do things and not making excuses for why I could not do them. It is amazing what you can find the time to do when it is made a priority. Everything we did is actually all in my blog. From where we shop to what we eat, how we treat viruses and colds and what we do in doctors offices.It is all in the blog. I have shared my cleaning recipes and how and when we use essential oils. You just need to scope out the blog. If you have any more questions or need more specific answers, feel free to email me.
Thank you for sharing my 11 year old son has been diagnosed with IGA and we have been suffering with illness after illness for the last two years – this gives me hope.
It was NOT an easy journey for her or us. However, it was worth it.
Hi!
Thank you for sharing your daughter story!
I was diagnosed with Iga nephrathy as well a few years ago! I would love some info on what you did as far as the essential oils.
Antoinette,
I rewrote the blog post about my daughter’s IgA. You can click here to see the updated version. If you still have any questions about what I did, please feel free to email me.
Thank you for giving me hope! Thank you. Thank you. Thank you. I was laying next to my husband (who was sound asleep, mind you) at 3:00 a.m. scouring the internet for anything remotely proactive. I was balling my eyes out, loosing all hope. Then I found this gem that has stopped the crying and has put me to work. My 5 year old boy was just diagnosed. I have a plan. Thank you for the gift of a plan! I can do this. Your blog will be my best friend and advocate. I will read every word you give me. Purchase essential oils and diffusers, check. Buy all the vingar, baking soda, and hydrogen peroxide I can find, check. Toss all the candles and toxins, check. Loaded the fridge with pro IGA foods aka low phosphate, potassium, salt and protiens,check…wait,Feingold Diet? Crap. Now it’s time to cook, crap…I’m going to drown. Say “when you have an autoimmune disease it’s not crazy” every time I want to throw up from stress, check. Just keep swimming…or reading in this case.
Hi Kari,
The one thing you need to remember is that this did not happen overnight for us. It took us several yrs of being EXTREMELY vigilant in doing everything I have listed. It was countless hours of research on my part. I was very overwhelming at first and I can not tell you how many times I thought I had it all figured out for us and then changed things up as I learned more. Feingold was extremely difficult and overwhelming at first because you remove a lot of foods and slwly add them back in over time. We also removed nitrates, nitrites, and other things from our diet. Eating out or eating over at friends and families, etc became something that is very limiting to my family. But worth it to us. I can not guarantee that this will work for you and your family. There may be things you need to shift and adjust differently as you go along on your journey. I am here to answer any questions you may have to the best of my abilities. You can reach me at simplicityredesigned@gmail.com.
This is wonderful! I was diagnosed with IGA Nephropathy when is was 15 . I am now 37. I’m so so thankful for this information! I would love to chat and ask more questions!
Feel free to send me an email!